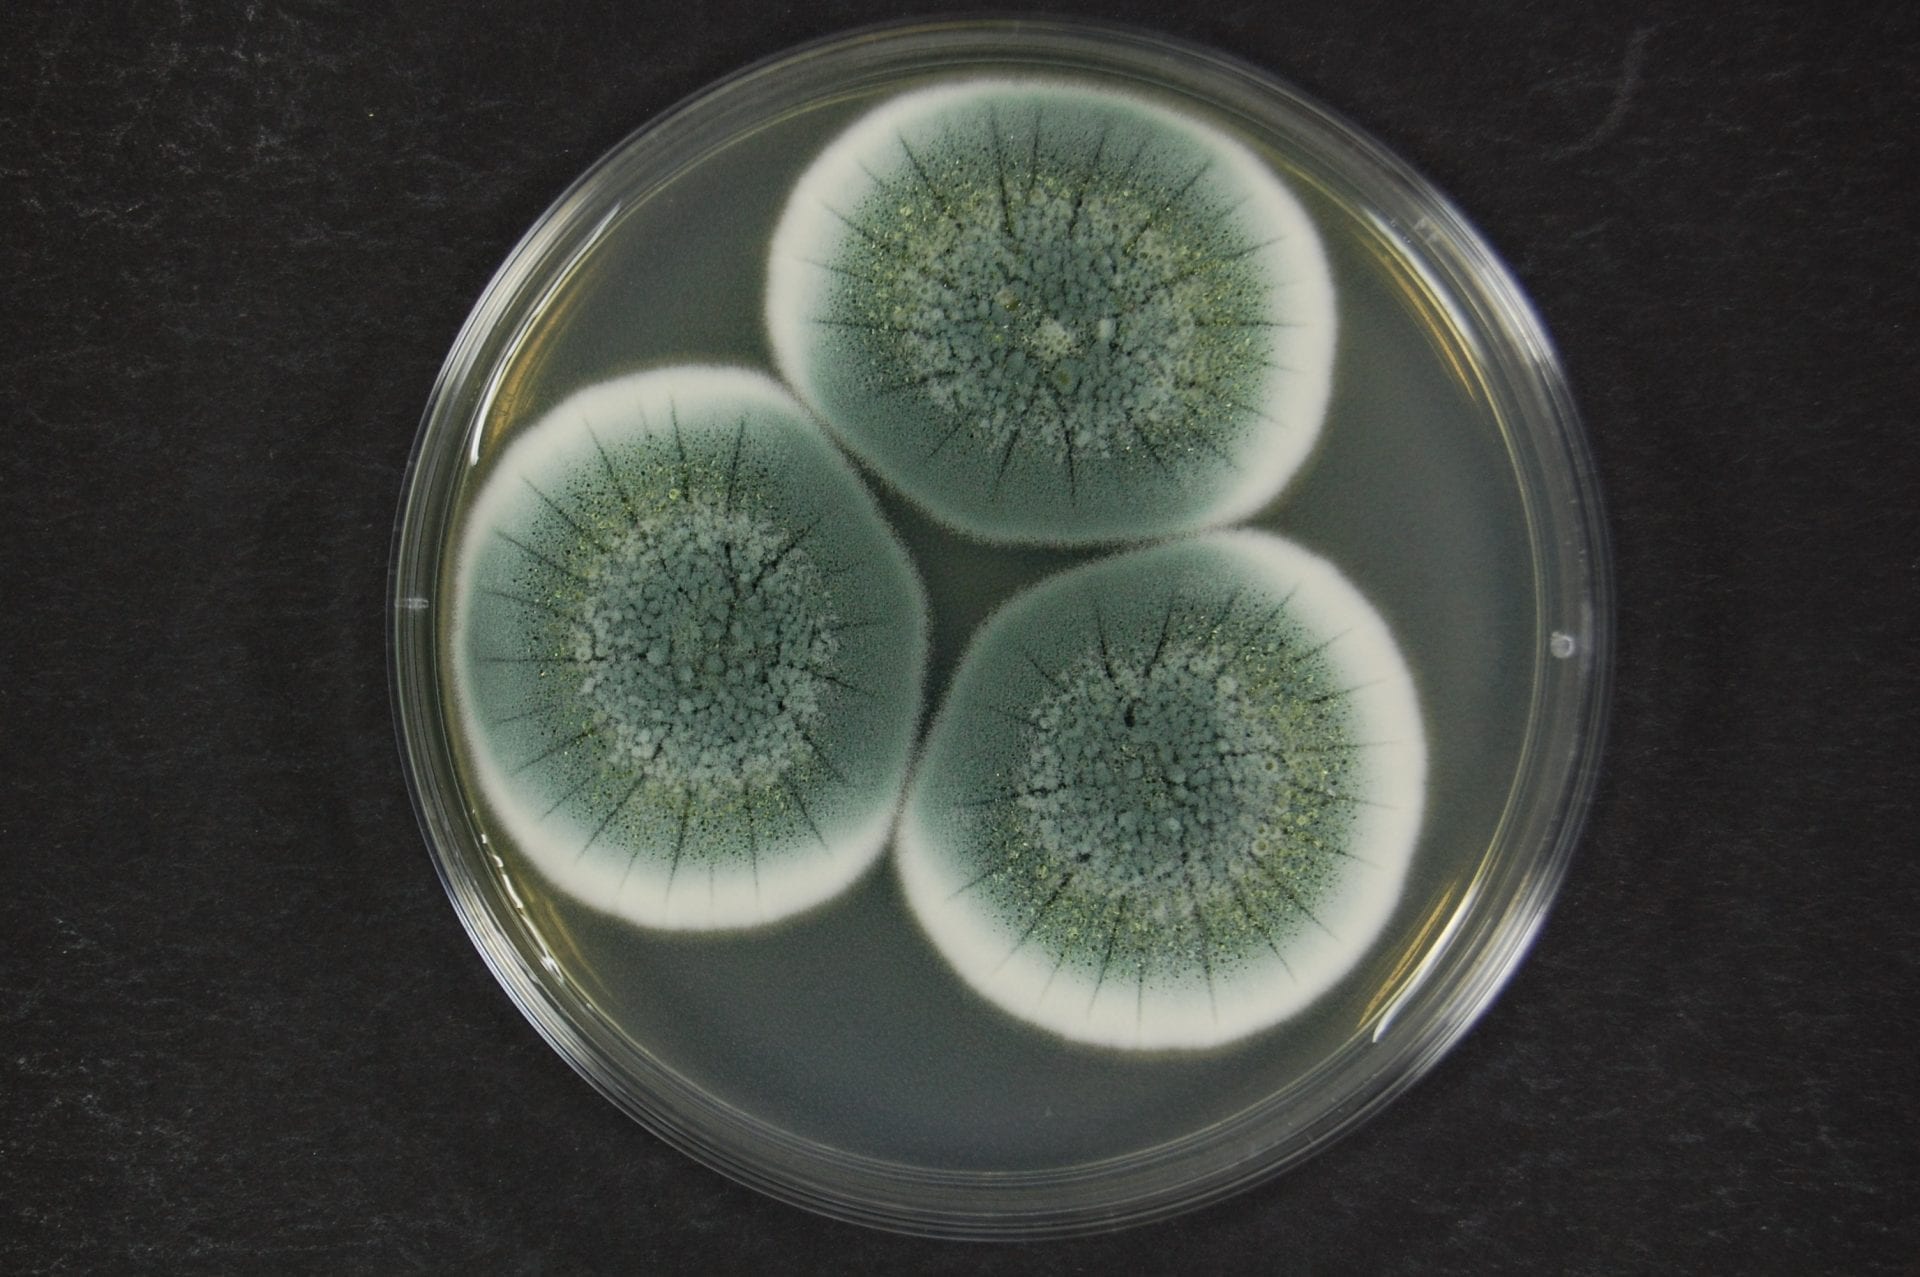

Пеницилл грипп
Пеницилл грипп 104 фото
Хочу отказаться от кредита
Колледж фряново
Путешествие к бессмертию превью
Топ лучших ручных миксеров
Играть в роблокс 32 бит
С чем едят хумус с кедровыми
Дождь во сне к чему снится мужчине
В каких случаях получаешь субсидию
Развитию микроорганизмов способствуют
Как быстро действует монурал при цистите
Останется лето до пятого класса песня слушать
Поем всей страной видео
Приобрела новую профессию
Антикор прим боди
Грузовики мустанг
Сколько звуков и букв в слове игрок
Игры для гостей на день рождения
Почему тупит ютуб сегодня
Места в ялте которые стоит посетить
Самый лучший квартира в москве